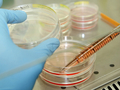
В США умер первый человек, заразившийся новым штаммом свиного гриппа

Свиной грипп

Медики: Вирус свиного гриппа становится резистентным к лекарствам
На сегодняшний день против вируса гриппа у медиков имеется всего два более или менее эффективных препарата - Тamiflu и Relenza. Как сообщается, к Тamiflu вирус все чаще оказывается невосприимчивым.

От свиного гриппа в Чили скончались 11 человек
Из-за вспышки свиного гриппа H1N1 на севере Чили скончались 11 человек, сообщают местные власти.

Ученые рассказали о побочных эффектах вакцинации от свиного гриппа
Британские ученые выявили, что следствие вакцинации от свиного гриппа может быть нарколепсия - дневная сонливость.

В Украине зарегистрировали два смертельных случая от гриппа
В Украине зарегистрированы два смертельных случая заболевания гриппом типа В и А (Н1) pdm09, сообщается в информационном бюллетене по гриппу и ОРВИ Государственной санитарно-эпидемиологической службы Украины.

В Грузии зафиксирована пятая смерть от свиного гриппа
В клинике в Тбилиси скончался молодой человек, который был доставлен из города Зугдиди с диагнозом "свиной грипп".

Свиным гриппом был инфицирован ''каждый пятый''
По меньшей мере каждый пятый был инфицирован свиным гриппом в первый год пандемии в 2009 году - об этом свидетельствуют данные, поступившие из 19 стран.

Медики не прогнозируют эпидемии свинного гриппа, но предупреждают о новом штамме вируса
Эпидемиологи уверены, что угрозы эпидемии свиного гриппа нет, однако они не исключают возвращения в Украину штамма вируса А(H1N1), более известного как свиной грипп

В Украине после праздников ожидают появления двух новых видов гриппа
Представители Института эпидемиологии подтвердил первый в этом году случай свиного гриппа, однако попросили не паниковать.

В легких свиней обнаружили сверхзаразный вирус гриппа
Международный коллектив вирусологов обнаружил в легких обычных свиней ранее неизвестный штамм вируса гриппа H1N2, способный заражать хорьков и человека воздушно-капельным путем и крайне негативно действующий на здоровье больных.
В США умер первый человек, заразившийся новым штаммом свиного гриппа
Официальные представители американского штата Огайо сообщили в пятницу о первом случае гибели человека, заразившегося новым штаммом свиного гриппа H3N2v, передает AP.

Ученые: Вакцина против свиного гриппа вызывает синдром мышечной слабости
Канадские ученые пришли к выводу, что вакцинация против свиного гриппа может спровоцировать развитие синдрома Гийена-Барре, острого полирадикулита у взрослых

Число смертей от свиного гриппа в мире в 15 раз выше, чем считалось ранее
Число смертей от высокопатогенного гриппа A/H1N1, известного также как свиной грипп, в 2009-2010 годах может быть в 15 раз выше, чем страны заявляли в своих докладах для Всемирной организации здравоохранения (ВОЗ).

Жертвами свиного гриппа в Индии стало 12 человек
Двенадцать человек скончалось от свиного гриппа, сообщает минздрав Индии. Врачи надеются, что вспышка будет кратковременной.










